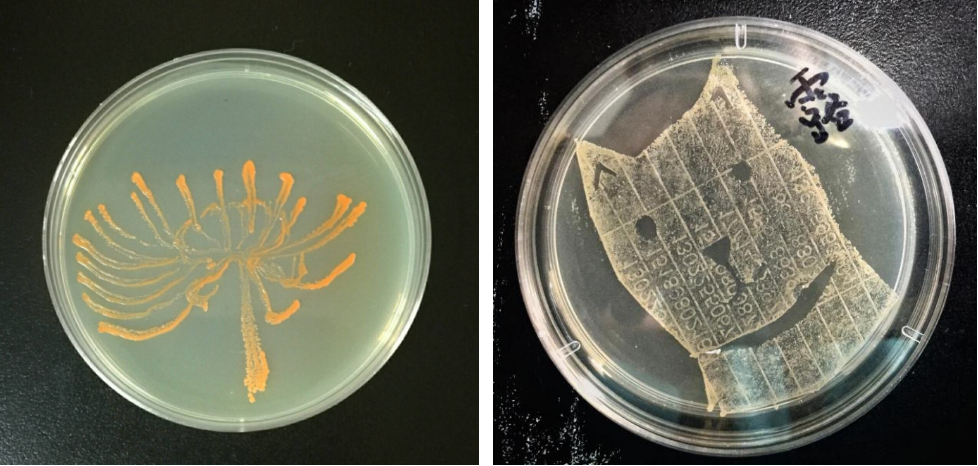

提起微生物,可能很多人会将“奇妙”、“高深”和“难以捉摸”等词汇与之相关联。而说到微生物工作者,人们脑海中更多会浮现刻板、认死理和缺乏生活情趣等形象。
然而,他们要是搞起艺术来,也会令人刮目相看、脑洞大开。
(1)“琼脂杯”艺术大赛
在固体琼脂平板上划线是微生物工作者的必备技能。
忙碌之余,用微生物在琼脂平板上画个画儿,是他们独特的放松方式。不满足于自娱自乐,这不,美国微生物学会就发起举办了微生物培养皿艺术大赛——“琼脂杯”艺术大赛。
英雄帖一经发出,世界各地的微生物工作者们便按捺不住他们的艺术之心,纷纷摩拳擦掌、热烈响应。培养基配起来,培养皿准备好,琼脂平板当画布,微生物们来集合……

图1:大法官Ruth Bader Ginsburg
许多种类的微生物能够产生色素,而这些可产色素的微生物们就成为了微生物画师们的绘图工具。显然,它们并不听话,在琼脂平板上作画的难度可想而知。
这些微生物艺术作品不仅难得,想要仿制更是近乎不可能,这可是只有微生物工作者们才能享受的乐趣哦。
(2)细菌冲印术
微生物学家扎卡里·柯普菲(Zachary Copfer)可谓有着很高的艺术造诣,他创造了一种名曰“细菌冲印术(Bacteriography)”的艺术形式。
他通过这种形式,冲印出了包括毕加索、达尔文、爱因斯坦和达芬奇等世界著名艺术家和科学家在内的诸多“微生物肖像画”。

图2:微生物肖像画
接下来,就让我们一起了解下具体的制作过程。
首先,在长宽均为24厘米的培养皿底部涂布黏质沙雷氏菌(拉丁学名:Serratia marcescens)。
随后,将肖像照片放置其上,进行辐射。由于照片会遮挡射线,故其下的黏质沙雷氏菌能够正常生长。当生长到一定时期后,培养皿上便会出现与照片肖像相类似的形象。
紧接着,再对整个培养皿进行辐射杀菌处理,并用透明的丙烯树脂将作品覆盖、固定,一副肖像画就冲印完成了。
(3)中国药科大学的微生物艺术
在琼脂平板上写字、画画是中国药科大学(简称“药大”)微生物学教研室的传统。老师们在本科教学过程中集思广益,积极发挥各自的艺术才能,寓教于乐,极大地提升了同学们的学习兴趣和主观能动性。图1就是他们和同学们制作的艺术作品“彼岸花”和“数码小狗”,挺棒的吧。
图3、微生物平皿画(左:彼岸花;右:数码小狗)
2016年,中国药科大学建校八十周年之际,微生物学教研室陈向东老师决定立足专业特色,为校庆奉上一份特殊贺礼。
她以药大华诞为主题,将微生物实验技术与传统剪纸艺术相融合,打造新型“艺术细菌”试验,并组织学生开展竞赛。
此外,为了兼顾安全性和艺术性,她还特地挑选了藤黄八叠球菌和金黄色葡萄球菌为供试菌株。
教师事事躬亲,同学们热烈响应。他们纷纷发挥自身想象力和艺术创造力,将细菌书写和紫外消毒技术结合运用,制作了药大Logo、“精业济群”(药大校训)、生日蛋糕、小天鹅、巨龙腾飞等多个艺术图案。
作品一经亮相便惊艳众人,迅速在师生中传播开来。在中国药科大学2016年的毕业晚会上,艺术细菌作品更是震撼登场,令全场惊叹不已。
毕业多年的药大校友们纷纷转发、转述,部分“艺术细菌”作品还被全国多家主流媒体所播报,药大官网、网易、新华网等网站也为此进行了专题报道。
2016年年底中国药科大学还承办了首届全国药学实验技能大赛,“艺术细菌”作为药大学生实验技能成果向全国八十多个兄弟院校进行了展示。

图4、中国药科大学八十周年校庆作品展

图5、中国药科大学2016年毕业晚会上的艺术细菌画
药大微生物人并没有止步于此,陈老师随后又带领张晶鑫等同学经过反复摸索和试验,将“艺术细菌”同我国传统版画艺术相结合,首创“细菌版画”这一艺术形式。
图4就是她们创作的细菌版画——药大镜湖风景,校友徐旭东还特意赋诗一首:“圣手丹青应叹服,药科才子意创殊。养培菌液挥文墨,倾注琼脂构画图。杏苑书香须细品,镜湖鸿鹄莫相辜。济群尚待能精业,沧海横流好悬壶。”

图6、药大镜湖风景(细菌版画)
微生物工作者就是这样的有范儿,就是那么的有才情雅趣,如果也想同他们一样,那就快快加入其中吧。
THE END
*本文为《胖魔王的微生物阵地》(微信号:nldxhjwswx)首发,任何媒体转载时须保留《胖魔王的微生物阵地》名称及微信号。未经许可,严禁对包括标题在内的任何改动。
*文中图片大部分引自网络,如不慎侵权请告知。欢迎朋友们就内容进行斧正,一切为了更好的科普!






 扫码下载APP
扫码下载APP

 科普中国APP
科普中国APP
 科普中国
科普中国
 科普中国
科普中国